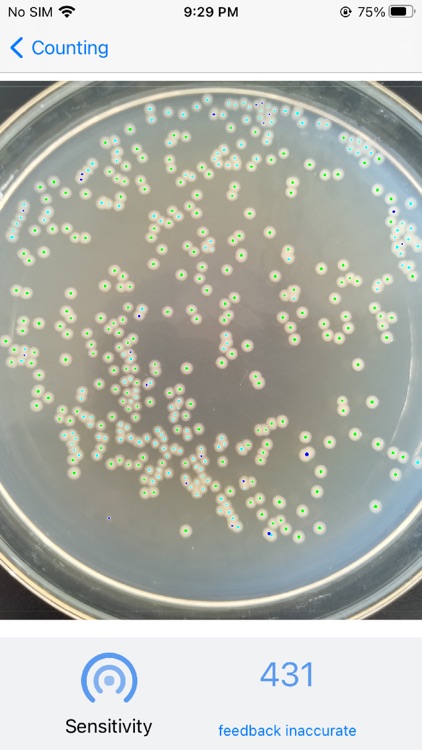
CountThings By Camera

【Introduction】
CountThings By Camera



What is it about?
【Introduction】

App Screenshots

App Store Description
【Introduction】
The precise point camera uses artificial intelligence combined with mobile apps, integrates computer vision capabilities into the mobile phone, can perform artificial intelligence analysis on the picture, and calculate the number of items in the picture. Compared with traditional image recognition, it has many advantages.
【Function】
1. Provide a constantly updated template library, users can select templates that meet their own requirements for statistics through the template library.
2. Provide two identification methods: taking pictures and selecting from albums
3. Provide area circle selection function to identify more accurately and quickly
4. Provide manual correction function, you can manually correct the results
5. Provide a history record function, you can save the results for later viewing
6. Provide a variety of items at the same time statistics function.
【Features/Advantages】
1. There is no requirement for the background of the picture. Traditional image recognition has very strict requirements on the background of the picture, and it can only be recognized under the background of a solid color. The precision point camera adopts a new generation of artificial intelligence counting, and there is no requirement for the background of the picture.
2. It has strong interference to the debris pit in the picture, the target object can be easily identified in the complex picture, and has a strong filtering effect on other debris interference.
3. There is no requirement for the size of the object, and items of various sizes can be counted, and there will be no wrong statistics due to size differences
4. Multi-class statistics, you can count a variety of classified items at one time, and calculate the number of each classified item.
5. Accurate statistics on complex items of various forms, and can count items with various forms, such as complex items such as people, can also be accurately counted.
6. Multi-classified nuanced statistics. It is possible to perform classification statistics on two very similar items, such as whether the medicine is defective.
【Currently supported items】
1. Agriculture and forestry: rice, red beans, black beans, soybeans, logs, Arabidopsis, peas
2. Breeding: small river shrimp, various sizes of fry, shrimp fry, fish eggs
3. Construction: steel bars, steel pipes
4. Biomedicine: bacterial colonies, cells
5. Society: people, bamboo sticks
6. More items are being supported, and you can also put forward your own needs in the software if necessary.
AppAdvice does not own this application and only provides images and links contained in the iTunes Search API, to help our users find the best apps to download. If you are the developer of this app and would like your information removed, please send a request to takedown@appadvice.com and your information will be removed.